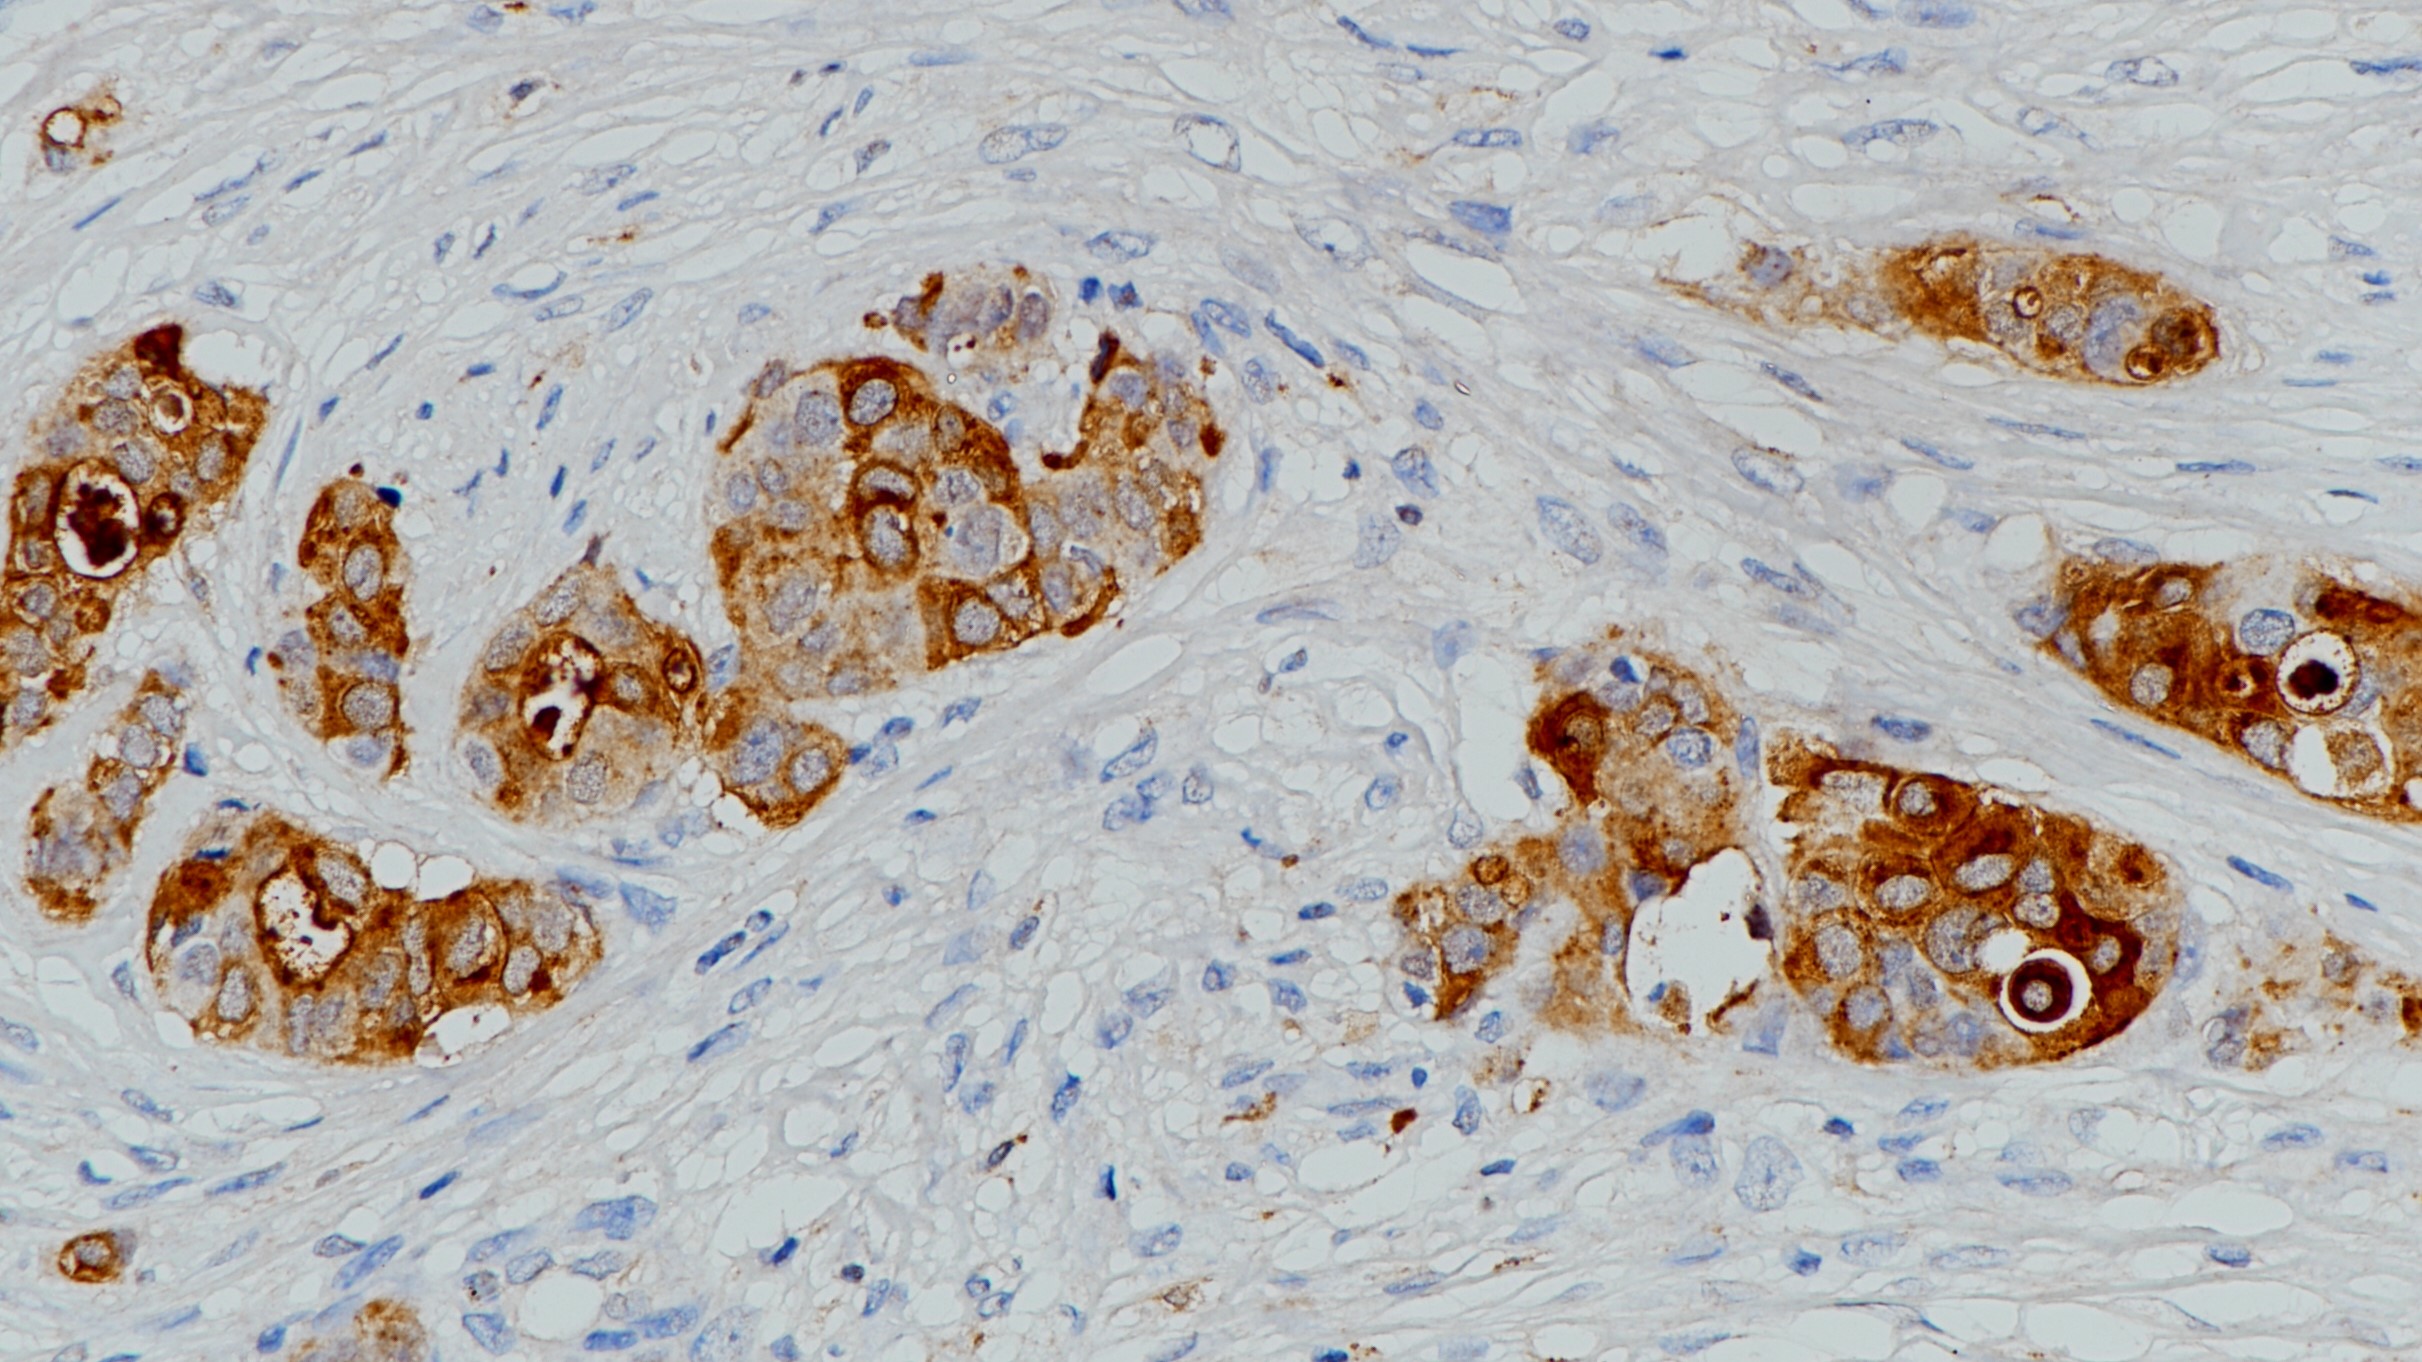
乳腺癌GCDFP-15(BP6118)染色

1. Jr D E H, Dilley W G, Mazoujian G, et al. Review of GCDFP‐15 An Apocrine Marker Protein.[J]. Annals of the New York Academy of Sciences, 2010, 586(1):161-173.
2. Chia S Y , Thike A A , Cheok P Y , et al. Utility of mammaglobin and gross cystic disease fluid protein-15 (GCDFP-15) in confirming a breast origin for recurrent tumors.[J]. The Breast, 2010, 19(5):355-359.